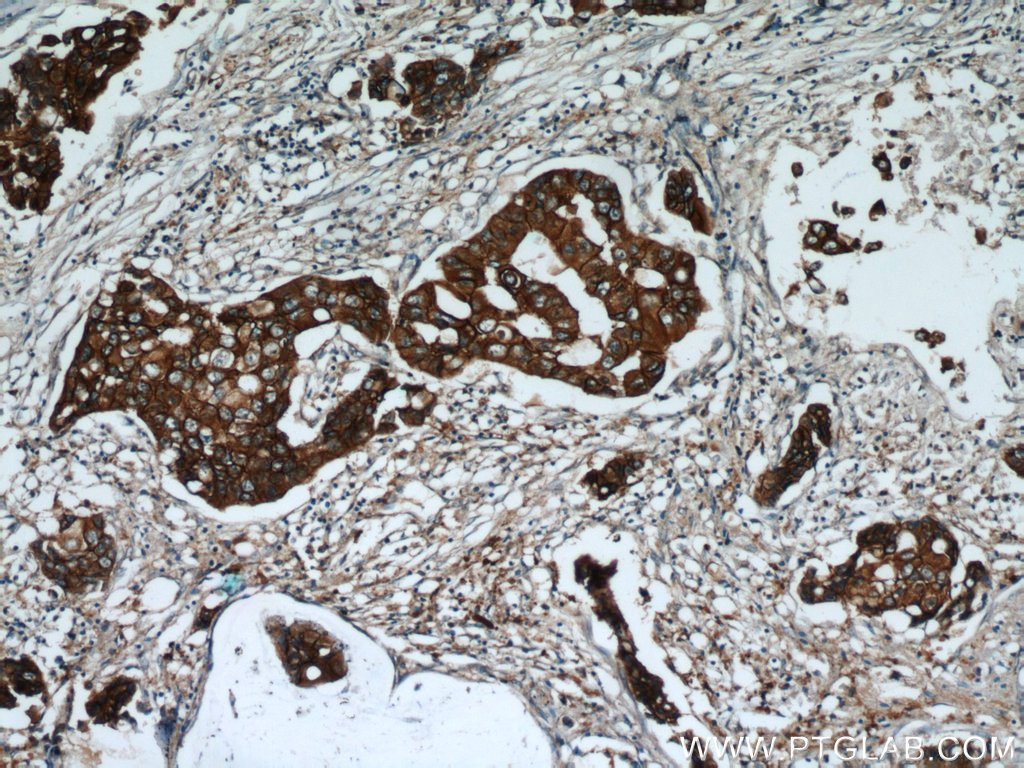

验证数据展示
经过测试的应用
| Positive WB detected in | 4T1 cells, SGC-7901 cells, MCF-7 cells, HeLa cells |
| Positive IP detected in | SGC-7901 cells |
| Positive IHC detected in | human breast cancer tissue, human ovary cancer tissue Note: suggested antigen retrieval with TE buffer pH 9.0; (*) Alternatively, antigen retrieval may be performed with citrate buffer pH 6.0 |
| Positive IF-Fro detected in | mouse breast cancer |
推荐稀释比
| 应用 | 推荐稀释比 |
|---|---|
| Western Blot (WB) | WB : 1:2000-1:12000 |
| Immunoprecipitation (IP) | IP : 0.5-4.0 ug for 1.0-3.0 mg of total protein lysate |
| Immunohistochemistry (IHC) | IHC : 1:300-1:1200 |
| Immunofluorescence (IF)-FRO | IF-FRO : 1:50-1:500 |
| It is recommended that this reagent should be titrated in each testing system to obtain optimal results. | |
| Sample-dependent, Check data in validation data gallery. | |
产品信息
18299-1-AP targets HER2/ErbB2 in WB, IHC, IF-Fro, IP, ELISA applications and shows reactivity with human, mouse samples.
| 经测试应用 | WB, IHC, IF-Fro, IP, ELISA Application Description |
| 文献引用应用 | WB, IHC, IF, IP |
| 经测试反应性 | human, mouse |
| 文献引用反应性 | human, mouse, rat, zebrafish |
| 免疫原 |
Peptide 种属同源性预测 |
| 宿主/亚型 | Rabbit / IgG |
| 抗体类别 | Polyclonal |
| 产品类型 | Antibody |
| 全称 | v-erb-b2 erythroblastic leukemia viral oncogene homolog 2, neuro/glioblastoma derived oncogene homolog (avian) |
| 别名 | ERBB2, CD340, HER 2, HER 2/neu, HER2 |
| 计算分子量 | 138 kDa |
| 观测分子量 | 185 kDa |
| GenBank蛋白编号 | BC167147 |
| 基因名称 | HER2/ErbB2 |
| Gene ID (NCBI) | 2064 |
| RRID | AB_2099264 |
| 偶联类型 | Unconjugated |
| 形式 | Liquid |
| 纯化方式 | Antigen affinity purification |
| UNIPROT ID | P04626 |
| 储存缓冲液 | PBS with 0.02% sodium azide and 50% glycerol, pH 7.3. |
| 储存条件 | Store at -20°C. Stable for one year after shipment. Aliquoting is unnecessary for -20oC storage. |
背景介绍
HER2, also known as ErbB2 and Neu, is a 185-kDa transmembrane glycoprotein that is a member of the epidermal growth factor (EGF) receptor family of receptor tyrosine kinases. It has no ligand-binding domain of its own and therefore cannot bind growth factors. However, it does bind tightly to other ligand-bound EGF receptor family members to form a heterodimer, stabilizing ligand binding and enhancing kinase-mediated activation of downstream signalling pathways, such as those involving mitogen-activated protein kinase and phosphatidylinositol-3 kinase. Amplification and/or overexpression of HER2 have been reported in numerous cancers, including breast and ovarian tumors. HER2 is a therapeutic target for the treatment of breast cancer and other carcinomas. This antibody raised against a synthesized peptide corresponding to 1237-1255aa of human HER2 recognizes the 185-kDa full-length glycosylated form and other lower molecular-mass forms of HER2, including the truncated form.
实验方案
| Product Specific Protocols | |
|---|---|
| IF protocol for HER2/ErbB2 antibody 18299-1-AP | Download protocol |
| IHC protocol for HER2/ErbB2 antibody 18299-1-AP | Download protocol |
| IP protocol for HER2/ErbB2 antibody 18299-1-AP | Download protocol |
| WB protocol for HER2/ErbB2 antibody 18299-1-AP | Download protocol |
| Standard Protocols | |
|---|---|
| Click here to view our Standard Protocols |
发表文章
| Species | Application | Title |
|---|---|---|
Signal Transduct Target Ther Circulating tumor cells shielded with extracellular vesicle-derived CD45 evade T cell attack to enable metastasis | ||
Cell Metab Targeting Erbin-mitochondria axis in platelets/megakaryocytes promotes B cell-mediated antitumor immunity | ||
Cell Res Protein C receptor is a therapeutic stem cell target in a distinct group of breast cancers. | ||
Small Efficient Delivery of GSDMD-N mRNA by Engineered Extracellular Vesicles Induces Pyroptosis for Enhanced Immunotherapy | ||
Nat Commun Targeting 17q23 amplicon to overcome the resistance to anti-HER2 therapy in HER2+ breast cancer. | ||
J Nanobiotechnology Accurate HER2 determination in breast cancer: a prominent COF-immobilized enzyme-enhanced electrochemical aptasensor employing 4-acetamidophenol as an efficient mediator |